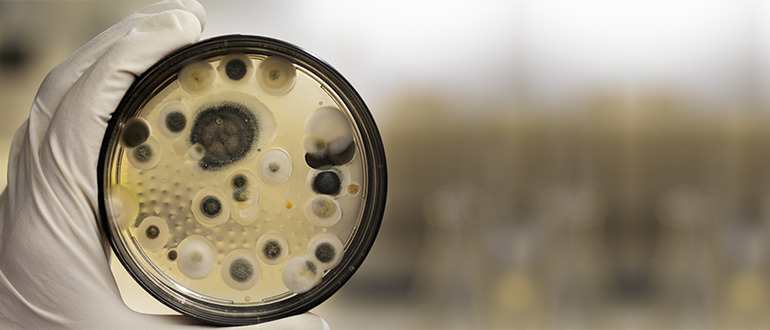

Što uzrokuje i kako se riješiti plijesni na zidovima?
Što uzrokuje i kako se riješiti plijesni na zidovima?
Plijesan se ne javlja samo na starim zidovima, već i kod novogradnje. Gdje god je vlage, postoji opasnost od pojave ovog neugodnog “dlakavog pokrivača” itekako opasnog po zdravlje.
- Blog
- Krajnji kupac - Investitor
Naravno, ukućani dišu, znoje se, tuširaju, kuhaju i peru. Ukratko, stalno oslobađaju vlagu koja se mora negdje pohraniti u kući ili stanu. "Ali to je sve potpuno normalno", kaže Mag. Brigitte Tassenbacher. Kao mikrobiolog i tehničar zaštite okoliša, njezina specijalnost su energetski učinkoviti oblici gradnje, a, uz dugogodišnje iskustvo kao certificirani stručnjak za plijesan, često savjetuje i kao vještak u sudskim sporovima.
Mjerenje temperature i vlažnosti u sredini prostorije obično pokazuje normalne vrijednosti: temperatura je oko 20 °C, a relativna vlažnost 50-55%. No, ako se mjeri na građevinskim površinama, poput vanjskih kutova zgrade, temperatura može pasti na 12 °C ili niže, a relativna vlažnost porasti na 80% ili više, što stvara idealne uvjete za rast plijesni.
Što projektanti mogu učiniti?

Šiljasti kutovi i konzolne komponente posebno pogodni su razvoj plijesni
Što graditelji mogu učiniti?
Kvaliteta nadzora i izvedbe gradnje ključna je nakon projektiranja. Prema Brigitte Tassenbacher, greške se često javljaju kada zidna ovojnica nije dovoljno nepropusna. Ako električari ili instalateri ne zatvore pravilno otvore, cijevi i kabele, topao i vlažan zrak može prodrijeti u zidne komponente. "To stvara idealne uvjete za nakupljanje vlage, što uzrokuje štetu na zgradama i daljnji rast gljivica".
Evo jednog primjera Brigitte Tassenbacher: Drvena greda na krovu bila je zaražena plijesni zbog hermetičke instalacije LED svjetiljke koja je osvjetljavala tuš nišu.Činjenica da se plijesan ne razvija na "mjestu zločina", već drugdje, je prilično uobičajena i može se pripisati različitim uvjetima tlaka. Također, korištenje vlažnih materijala tijekom gradnje može uzrokovati vlagu i pojavu plijesni na zidovima.
Postoji li ikakvo rješenje?

Hoval HomeVent svestrana je komforna stambena ventilacija koja lako se uklapa u Vaš dom.
